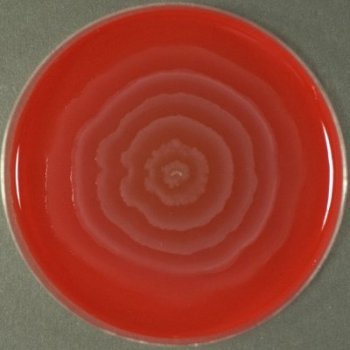

What organism is this?
(Blood Agar)
Proteus mirabilis
Swarming on blood agar
What are the general characteristics of Enterobacteriaceae?
Gram-negative rod shaped organisms
Ability to reduce nitrates to nitrites (NO3->NO2)
Inability to produce the respiratory enzyme oxidase (oxidase negative)
Facultative anaerobic metabolism (prefers oxygen reduced environment)
Fermentation of glucose (glucose positive)
Growth on MacConkey agar
What tests are part of IMViC?
What is a positive result?
Used to identify an organism in the coliform group (a gram negative aerobic/non-aerobic lactose producing rod)
I: Indole- tests organism for indole production
POSITIVE: a pink/red layering forming on the top of the liquid
M: Methyl Red- detects fermentation of glucose based on acids produced
POSITIVE: red color change
V: VP- tests to see if bacteria can produce acetoin from fermenting glucose
POSITIVE: red color change
C: Citrate: determines if an organism can use citrate for it’s sole carbon source
POSITIVE: blue color change
Which Enterobacteriaceae are lactose positive?
Which Enterobacteriaceae are lactose negative?
What is the most common clinical isolate?
Eschericha coli
Which Enterobacteriaceae are non-motile?
How would you differentiate these two organisms?
Which organism is a lactose positive H2S producer?
Citrobacter
Are Pseudomonas and Vibro enterobacteriaceae?
NO
Serratia an Yersinia are _________ (common/rare) clinical isolates.
rare
Which lactose positive organism is indole postitive?
E. coli
Which lactose positive organisms are citrate and VP positive?
How would you differentiate between the two?
Klebsiella (non-motile)
Enterobacter (motile)
Describe the Lysine Iron Agar slant test
Tests for glucose fermentation, lysine decarboxylation, lysine deamination, and H2S production.
LIA Slant- interpret slant number 3

purple slant/ purple butt
Alkaline slant/ Alkaline butt
K/K
Lysine decarboxylation
No glucose fermentation
LIA slant- interpret tube #1

Purple slant/ yellow butt
Alkaline slant/ Acid butt
K/A
Glucose fermentation
LIA slant- interpret slant # 2

Red slant/ yellow butt
Red slant/ alkaline butt
R/A
Lysine Deamination
Glucose fermentation
LIA slant- interpret slant #4

H2S production
Describe the Triple Sugar Iron Agar slant
Tests and organisms abilty to ferment glucose, lactose, sucrose and tests for gas production and H2S.
TSI slant- interpret slant number 2

Red slant/ Yellow Butt
Alkaline slant/ acid butt
K/A
Glucose positive (glucose only)
TSI slant- interpret slant #4

Yellow slant/ yellow butt
Acid slant/ Acid butt
A/A
Glucose + Lactose/Sucrose positive
*** this also shows gas production
TSI slant- interpret slant #1

Red slant/ red butt
alkaline slant/ alkaline butt
K/K
No fermentation
TSI slant- interpret slant #3

H2S production
Describe the urea hydrolysis test (Christiansen’s).
What is a positive result?
Tests an organisms ability to produce the enzyme urease.
POS: magenta
NEG: light orange
E. coli is normal flora in which part of the body?
The gut